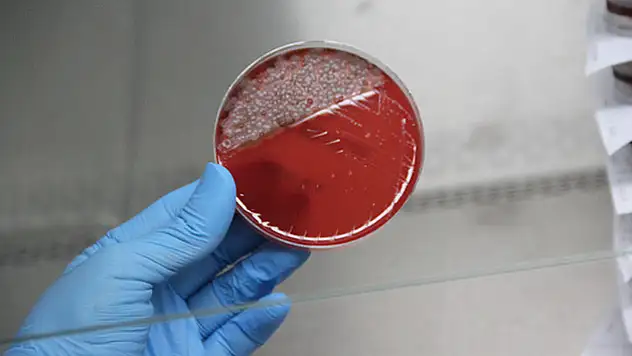
Uzun süre kullanılan maskedeki bakteriler laboratuvarda gözler önüne serildi

ter
Ter haberleri ve son dakika gelişmelerine ait tüm haberleri listeleyin.

Van 2006 Kültür Ve Turizm Envanteri Tarihsel Değerler

Van’da PKK terör örgütüne ait silah ve mühimmat el geçirildi

İngiltere'de son 24 saatte 27 bin 301 yeni vaka

Başkale'de terör örgütüne ait silah ve patlayıcı ele geçirildi

Bakanın örnek gösterdiği Tekirdağ için korkutan harita

Van’da terör örgütüne ait silah ve mühimmat ele geçirildi

İngiliz araştırmacılardan dikkat çeken çalışma: 'Covid-19 akıl sağlığını tehdit ediyor'

AZERBAYCAN RUS HELİKOPTERİNİ DÜŞÜRDÜ

Babacan'dan 'güçlendirilmiş parlamenter sistem' için 6 madde

BM Genel Sekreteri'nin Libya Özel Temsilci Türkiye'ye geliyor

Saray'da terör örgütüne darbe

HATAY'DA PATLAMA

Ermenistan ordusunda ateşkes ihlali
Uzun süre kullanılan maskedeki bakteriler laboratuvarda gözler önüne serildi

İngiltere'de son 24 saatte 20 bin 530 yeni vaka

180. MÜŞTERİYE PTT’DEN HEDİYE

Yargıtay'ın hastalıkta kıdem tazminatı kriterleri

Turizmciler Kapıköy Sınır Kapısı için bir araya geldi

İngiltere'den Rusya'ya siber saldırı suçlaması

TURNUVANIN EN CENTİLMEN TAKIMI VAN MASTERLER SEÇİLDİ

Erciş Belediyesi sokak hayvanlarını unutmuyor

Altan Tan: HDP, ya PKK'nın sürdürdüğü siyaseti sürdürecek ya da yeter diyecek

VANLI MASTERLER YARI FİNALDE

Polis ve ailesi tarafından ikna edilen terörist teslim oldu

Enerji verimliliği kriterinde değişiklik

VANLI MASTERLER FARKLI KAZANDI: 5-2

Van'da yakalanan terörist tutuklandı

Virüs en çok ABD, Brezilya, Hindistan, İngiltere, Fransa gibi ülkelerde ölüme neden oldu

Jandarma helikopteri yeni doğan bebek için havalandı

İngiltere'de 8 Mayıs'tan bu yana en yüksek günlük korona vakası

CHP Van İl Başkanı Kurukcu: Denetimler yetersizdir

'Scooter'a yasal düzenleme geliyor! TCDD'de scooter işine giriyor

Atak helikopter pilotundan Van jesti

VANSPORLU TERZİ MUSTAFA HAYATINI KAYBETTİ

Azerbaycan Cumhurbaşkanı Aliyev'den Doğu Akdeniz mesajı: 'Türkiye'yi tereddütsüz destekliyoruz'

Van Valiliği: “PKK/KCK terör örgütünde kopmalar ve kayıplar arttı”

Fakülte sekreteri dede koronadan hayatını kaybetti

Genel Sekreter Yardımcısı Özvan minibüslerin güzergâhını inceledi

Mesleki Yeterlilik belgesine sahip kadın çalışanların sayısı 50 bini aştı

DEFTERDARLIK BİNASI İNŞAATI NEDEN BİTMİYOR?